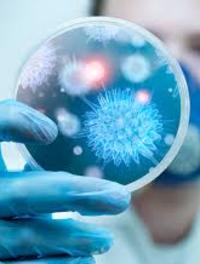

Une nouvelle peau pour la dermato
24e Congrès mondial de dermatologie
Du 10/06/2019 au 15/06/2019
- Milan

En 1889, il y a donc 130 ans, se tenait le premier congrès international (ne disons pas mondial) de dermatologie à Paris regroupant [...]